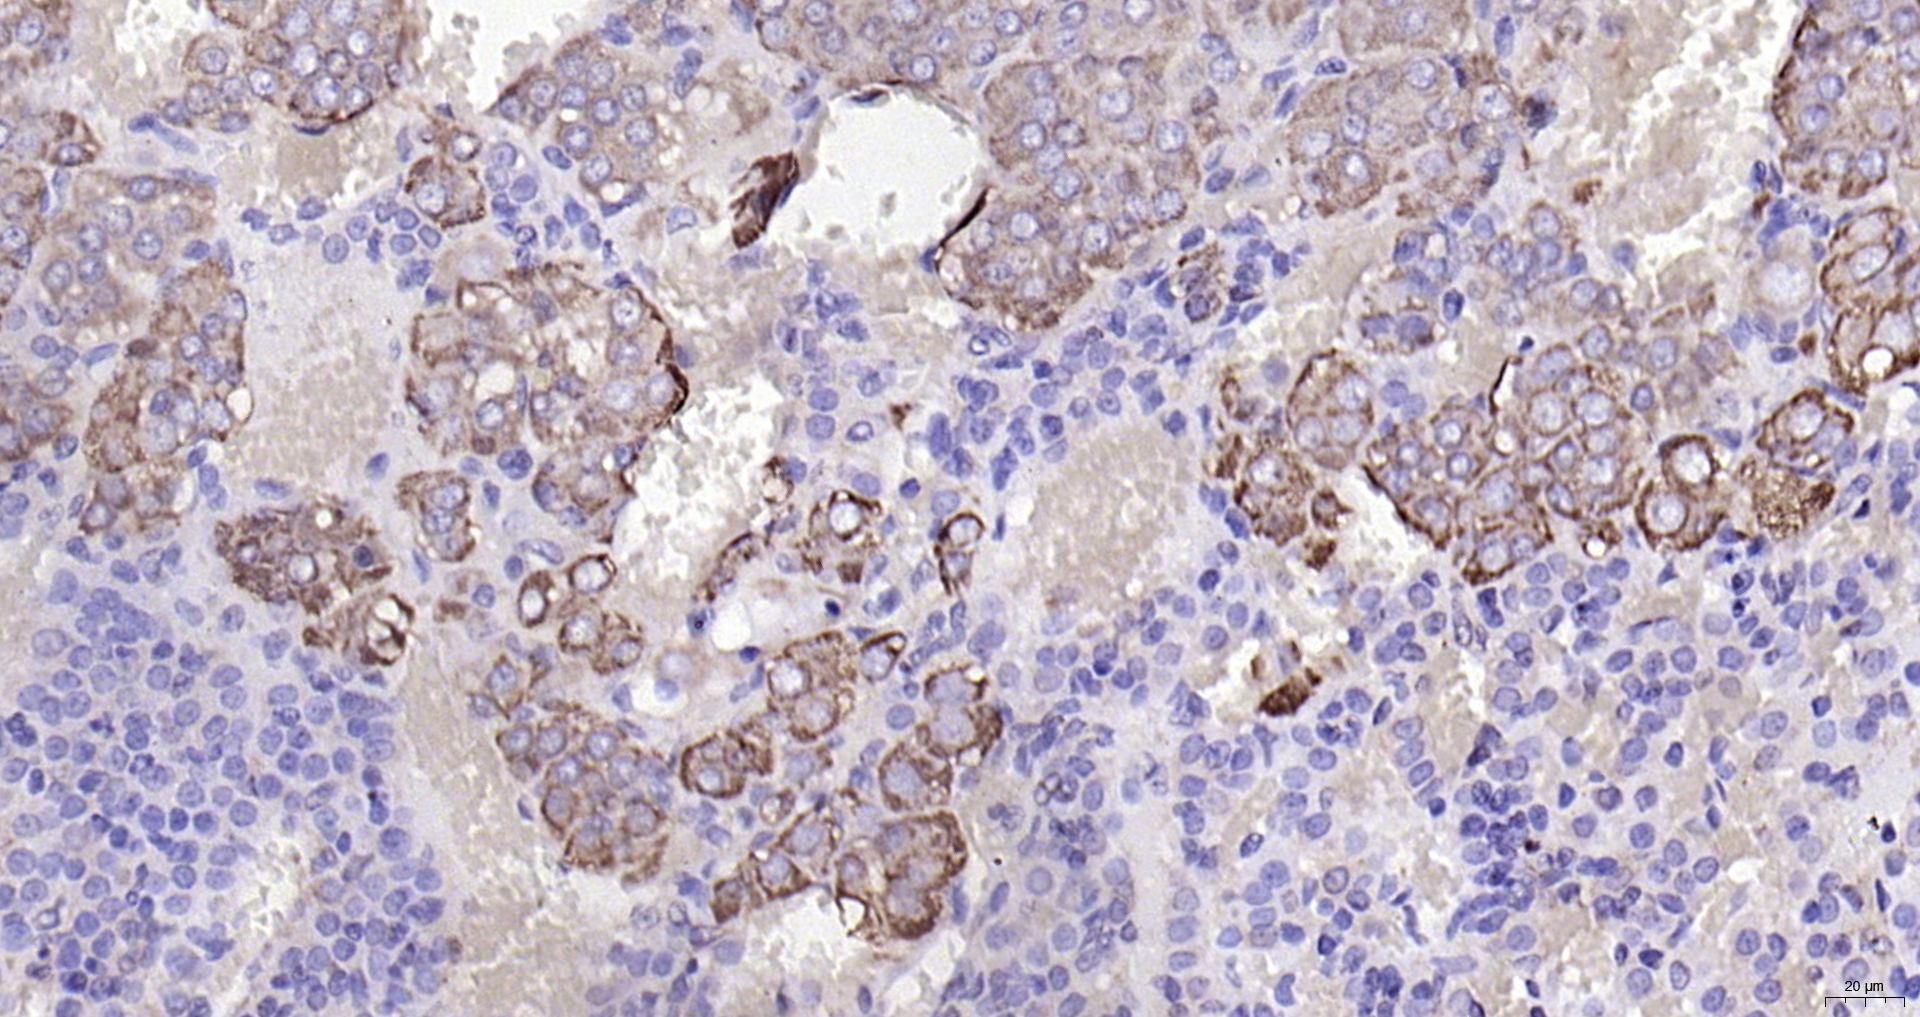

Mouse brain lysates probed with Rabbit Anti-CHRNA7 Polyclonal Antibody, Unconjugated (bs-1049R) at 1:300 overnight at 4˚C. Followed by conjugation to secondary antibody (bs-0295G-HRP) at 1:500 for 90 min at 37˚C.
CHRNA7 Polyclonal Antibody
BS-1049R
ApplicationsImmunoFluorescence, Western Blot, ELISA, ImmunoCytoChemistry, ImmunoHistoChemistry, ImmunoHistoChemistry Frozen, ImmunoHistoChemistry Paraffin
Product group Antibodies
TargetCHRNA7
Overview
- SupplierBioss
- Product NameCHRNA7 Polyclonal Antibody
- Delivery Days Customer16
- ApplicationsImmunoFluorescence, Western Blot, ELISA, ImmunoCytoChemistry, ImmunoHistoChemistry, ImmunoHistoChemistry Frozen, ImmunoHistoChemistry Paraffin
- Applications SupplierWB(1:300-5000), ELISA(1:500-1000), IHC-P(1:200-400), IHC-F(1:100-500), IF(IHC-P)(1:50-200), IF(IHC-F)(1:50-200), IF(ICC)(1:50-200)
- CertificationResearch Use Only
- ClonalityPolyclonal
- Concentration1 ug/ul
- ConjugateUnconjugated
- Gene ID1139
- Target nameCHRNA7
- Target descriptioncholinergic receptor nicotinic alpha 7 subunit
- Target synonymsCHRNA7-2, NACHRA7, nAChR7, neuronal acetylcholine receptor subunit alpha-7, a7 nicotinic acetylcholine receptor, alpha 7 neuronal nicotinic acetylcholine receptor, alpha-7 nicotinic cholinergic receptor subunit, cholinergic receptor, nicotinic alpha 7, cholinergic receptor, nicotinic, alpha 7 (neuronal), cholinergic receptor, nicotinic, alpha polypeptide 7, neuronal acetylcholine receptor protein, alpha-7 chain, nicotinic acetylcholine receptor subunit alpha-7
- HostRabbit
- IsotypeIgG
- Protein IDP36544
- Protein NameNeuronal acetylcholine receptor subunit alpha-7
- Storage Instruction-20°C
- UNSPSC41116161
References
- Brainstem cholinergic pathways diminish cardiovascular and neuroinflammatory actions of endotoxemia in rats: Role of NFkappaB/alpha7/alpha4beta2AChRs signaling. Sallam MY et al., 2019 Oct, NeuropharmacologyRead this paper
- Effect of splenectomy on attenuation of LPS-induced AKI through GTS-21-induced cholinergic anti-inflammatory pathway. Gao Y et al., 2019, Am J Transl ResRead this paper